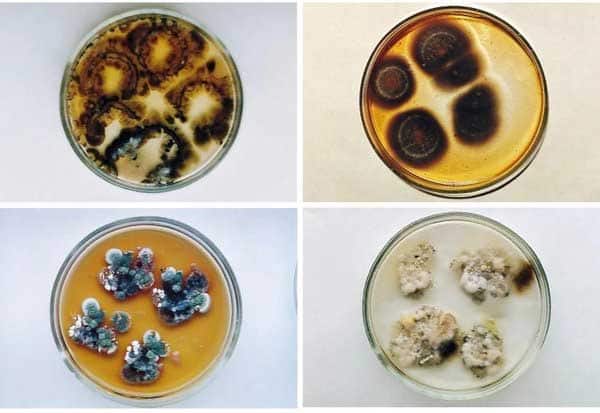
Image 1503721

PUBLISHED ON : டிச 04, 2025 07:41 AM

1. மாரடைப்பால் சேதம்அடைந்த இதயத் திசுக்களை சீர்செய்ய, 'நுண் ஊசிப் பட்டை' ஒன்றை டெக்சாஸ் பல்கலை உருவாக்கியுள்ளது. பட்டையை இதயத்தின் மேல் ஒட்டியதும், 'ஐ.எல்., -4' எனும் புரதத்தை திசுக்களில் பாய்ச்சிவிட்டு நுண் ஊசிகள் கரைந்துவிடும். விலங்கு சோதனைகளில், சேதமடைந்த இதயத் திசுக்கள் குணமடைந்தன.
![]() |
2. செர்னோபில் அணு உலையின் இடிபாடுகளில் வளரும் ஒரு கருப்பு பூஞ்சை, கதிர்வீச்சையே உணவாகக் கொண்டு வளர்கிறது. அதிகளவு 'மெலனின்' கொண்ட இந்தப் பூஞ்சைகள், கதிர்வீச்சை உயிரியல் ஆற்றலாக மாற்றுகின்றன.
![]() |
3. பாக்டீரியாக்களை ஆன்டிபயாடிக் மருந்து மூலம் கொல்லாமல், முட்களால் கிழித்துக் கொல்லும் பொருளை ஸ்வீடனின் சால்மெர்ஸ் பல்கலை உருவாக்கியுள்ளது. அப்பொருள், உலோகம், கரிமம் என ஈரடுக்கால் ஆனது. அதன் மேற்பரப்பில் உள்ள முட்கள், அதன் மீது அமரும் கிருமிகளைத் துளைத்து அழிக்கின்றன. இதனால், மருந்து இல்லாமலேயே பாக்டீரியாக்கள் அழிக்கப்படுகின்றன.
![]() |
4. மூளைக் கட்டியை அழிக்க, மூக்கு வழியாக செலுத்தப்படும் தங்கத் துகள் நானோ மருந்தை, வாஷிங்டன் பல்கலை உருவாக்கியுள்ளது. இது கட்டிகளை அழிப்பதோடு நீண்டகால எதிர்ப்பு சக்தியையும் தருகிறது என்பது எலிகளிடம் நடந்த சோதனையில் உறுதியாகியுள்ளது.
![]() |
5. லேசர்கள் மற்றும் சூரிய மின்பலகைகளின் செயல்திறனைப் பன்மடங்கு அதிகரிக்க, 'பெரோவ்ஸ்கைட்' படிகங்களை நானோ அளவில் அடுக்குகளாக அமைக்கும் முறையை ஆய்வாளர்கள் முன்னெடுத்துள்ளனர். மிக மெல்லிய இந்த அடுக்குகளை துல்லியமாக வடிவமைப்பதன் மூலம், அடுத்த தலைமுறை ஒளியியல் கருவிகளை உருவாக்கலாம்.